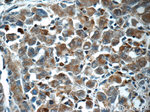
ITPKC Antibody in Immunohistochemistry (Paraffin) (IHC (P))
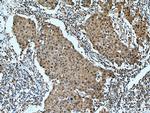
ITPKC Antibody in Immunohistochemistry (Paraffin) (IHC (P))

Search
Proteintech
ITPKC Polyclonal Antibody
{{$productOrderCtrl.translations['antibody.pdp.commerceCard.promotion.promotions']}}
{{$productOrderCtrl.translations['antibody.pdp.commerceCard.promotion.viewpromo']}}
{{$productOrderCtrl.translations['antibody.pdp.commerceCard.promotion.promocode']}}: {{promo.promoCode}} {{promo.promoTitle}} {{promo.promoDescription}}. {{$productOrderCtrl.translations['antibody.pdp.commerceCard.promotion.learnmore']}}
产品信息
14267-1-AP
种属反应
宿主/亚型
分类
类型
抗原
偶联物
形式
浓度
规格
纯化类型
保存液
内含物
保存条件
运输条件
产品详细信息
Immunogen sequence: MRRCPCRGS LNEAEAGALP AAARMGLEAP RGGRRRQPGQ QRPGPGAGAP AGRPEGGGPW ARTEGSSLHS EPERAGLGPA PGTESPQAEF WTDGQTEPAA AGLGVETERP KQKTEPDRSS LRTHLEWSWS ELETTCLWTE TGTDGLWTDP HRSDLQFQPE EASPWTQPGV HGPWTELETH GSQTQPERVK SWADNLWTHQ NSSSLQTHPE GACPSKEPSA DGSWKELYTD GSRTQQDIEG PWTEPYTDGS QKKQDTEAAR KQPGTGGFQI QQDTDGSWTQ PSTDGSQTAP GTDCLLGEPE DGPLEEPEPG ELLTHLYSHL KCSPLCPVPR LIITPETPEP EAQPVGPPSR VEGGSGGFS (1-358 aa encoded by BC060788 )
靶标信息
Inositol 1, 4, 5-trisphosphate 3-kinase (ITPK) catalyzes the phosphorylation of Ins(1, 4, 5)P3 to Ins(1, 3, 4, 5)P4, both of which are modulators of calcium homeostasis. ITPK isoforms include ITPKA, ITPKB, and ITPKC, all of which contain a conserved catalytic unit in their C termini, but have unique N-terminal sequences and tissue distributions.
仅用于科研。不用于诊断过程。未经明确授权不得转售。
篇参考文献 (0)
生物信息学
蛋白别名: Inositol 1,4,5-trisphosphate 3-kinase C; Inositol-trisphosphate 3-kinase C; InsP 3 kinase C; insP 3-kinase C; IP3 3-kinase C; IP3K C
基因别名: IP3-3KC; IP3KC; ITPKC
UniProt ID: (Human) Q96DU7
Entrez Gene ID: (Human) 80271